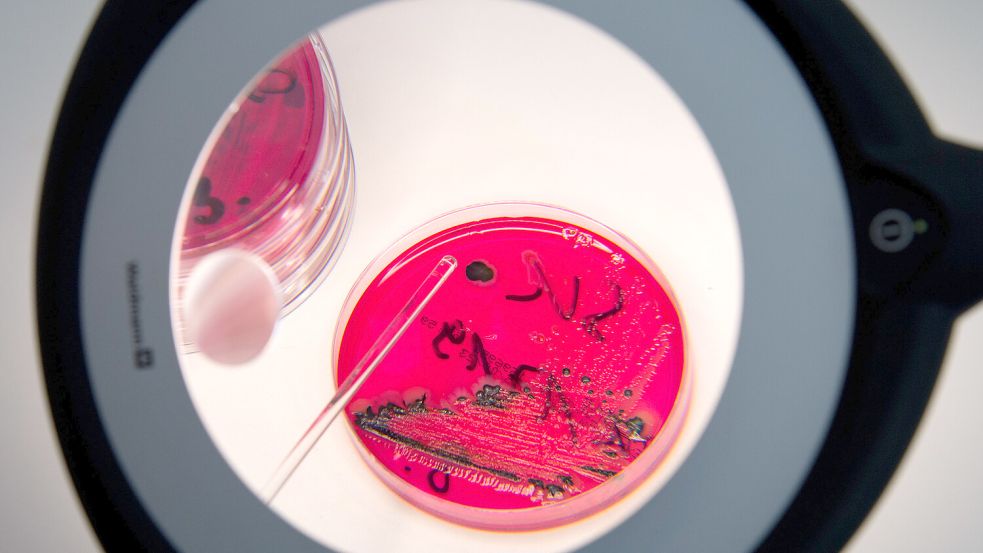

Warnmeldungen zu Lebensmitteln Rückruf für Geflügel-Fleischwurst von Edeka

Wer „gut & günstig“ Delikatess Geflügel Fleischwurst von Edeka im Kühlschrank hat, sollte das Haltbarkeitsdatum prüfen. In einer Charge wurden Bakterien entdeckt, die krank machen können.
Ostfriesland - Plastiksplitter, Salmonellen oder fehlende Hinweise auf allergene Zutaten – es gibt ganz unterschiedliche Gründe, aus denen Lebensmittel vom Hersteller zurückgerufen werden. Hier informieren wir über solche Fälle.
Listerien in Geflügel-Fleischwurst
Aufgrund des Nachweises von Listerien macht das Niedersächsische Ministerium für Ernährung, Landwirtschaft und Verbraucherschutz darauf aufmerksam, dass das Produkt Delikatess Geflügel Fleischwurst (Chargennummer 71396010834, Mindesthaltbarkeitsdatum 01.08.2024), das in Niedersachsen ausschließlich bei Edeka erhältlich ist, zurückgerufen wird. Edeka hat den Angaben nach einen öffentlichen Rückruf des „gut & günstig“-Produkts veranlasst. Noch in den Filialen befindliche betroffene Ware wird demnach aus den Regalen genommen. Das Verbraucherschutzministerium warnt davor, das Produkt zu verzehren.
Die Verunreinigung mit Listerien wurde bei einer Untersuchung von Proben in Baden-Württemberg festgestellt. Das Verbraucherschutzministerium wurde über das Ergebnis am Mittwoch, 17. Juli 2024, informiert. Die zuständigen kommunalen Behörden überwachen laut Ministerium den Rückruf. Die behördlichen Ermittlungen dauern an.
Eine Listerien-Erkrankung äußert sich meist innerhalb von 14 Tagen nach Infektion mit Durchfall und Fieber. Insbesondere Schwangere, Senioren und Menschen mit geschwächtem Abwehrsystem können auch schwerere Krankheitsverläufe mit Blutvergiftung und Hirnhautentzündung entwickeln. Bei Schwangeren kann, sogar ohne Symptome, das ungeborene Kind geschädigt werden.
Edeka und Marktkauf: Rückruf für Räucherlachs
Wer norwegischen Räucherlachs der Marke „gut & günstig“ bei Edeka oder Marktkauf in Niedersachsen und Nordrhein-Westfalen gekauft hat, sollte das Haltbarkeitsdatum genau prüfen. Der Hersteller Laschinger Seafood hat am Dienstag, 4. Juni 2024, die 200-Gramm-Packung zurückgerufen. Der Grund: Es ist teilweise ein falsches Verbrauchsdatum aufgedruckt worden. Auf der Rückseite der Verpackung sei aufgrund eines Systemfehlers statt dem 10. Juni der 10. Juli als Verbrauchsdatum zu finden, wie das Unternehmen mit Sitz im bayerischen Deggendorf mitteilte. Der Rückruf wurde auf dem Internetportal lebensmittelwarnung.de veröffentlicht. Er ist hier zu finden.
Die betroffenen Packungen wurden aus den Supermarktregalen genommen. Wer ein Paket zuhause hat, kann es auch ohne Kassenbon wieder zurückgeben und bekommt den Kaufpreis erstattet. Andere Packungsgrößen oder Haltbarkeitsdaten sind laut Hersteller nicht betroffen.
Zu hohe Pflanzenschutzmittel-Werte in Kartoffeln gefunden
Die Märkte Rewe und Penny raten dringend vom Verzehr einer bestimmten Sorte von Speisefrühkartoffeln ab. Betroffen von dem Rückruf, der am 27. Mai 2024 bekannt wurde, ist die Sorte Lilly, mehligkochend, 2,0 Kilogramm, mit der Chargen-Nummer 463065, die bei Rewe unter der Marke „Rewe Beste Wahl“ sowie bei Penny unter dem Label „Penny-Marktliebe“ verkauft wird.
Grund für den vorsorglichen Rückruf der betroffenen Charge ist der Nachweis eines Pflanzenschutzmittels über dem gesetzlichen Rückstandshöchstgehalt, heißt es in einer Mitteilung. Eine Gesundheitsgefährdung könne nicht mit abschließender Sicherheit ausgeschlossen werden. Deshalb wird vom Verzehr des betroffenen Produktes dringend abgeraten. Die betroffenen Kartoffeln wurden inzwischen aus dem Verkauf genommen.
Kunden können das Produkt im Markt zurückgeben und bekommen den Kaufpreis erstattet, auch ohne Vorlage des Kassenbons, teilt Rewe mit. Rückfragen können Kunden werktags von 8 bis 16 Uhr telefonisch unter der Nummer 02166/9681950 sowie per E-Mail stellen.

Metallteile in „Knusperdinos“?
Wer die „Knusperdinos“ von Edeka in seinem Haushalt hat, sollte das Mindesthaltbarkeitsdatum prüfen. Für bestimmte Packungen gibt es einen Rückruf wegen möglicher Fremdkörper aus Metall in der Verpackung. Der Lebensmittelhersteller Paul Daut aus Rheda-Wiedenbrück in Nordrhein-Westfalen hat am Dienstag, 14. Mai 2024, einen entsprechenden Rückruf gestartet. Nach Angaben des Portals lebensmittelwarnung.de ist das Produkt „Gut & Günstig Knusperdinos“ mit 400 Gramm mit dem Mindesthaltbarkeitsdatum 3. April 2025 betroffen. Vertrieben wurde das Produkt über Edeka in Niedersachsen, Bayern, Hamburg, Hessen, Mecklenburg-Vorpommern und Schleswig-Holstein. Wer diese „Knusperdinos“ im Haus hat, kann sie auch ohne Kassenbon wieder zurückgeben. Anfragen dazu beantwortet der Kundenservice von Edeka per E-Mail unter info@edeka.de oder telefonisch von Montag bis Sonntag in der Zeit von 8 bis 20 Uhr unter 05242/590492.

Plastikteile im Toast bei Edeka und Lidl
Das Unternehmen Bakkerij Holland aus den Niederlanden hat die Weizen- sowie Vollkorn-Sandwich-Toasts der Marke „Gut&Günstig“ zurückgerufen. In den betroffenen 750-Gramm-Packungen können weiße Plastikteile enthalten sein. Der Rückruf wurde am Freitag, 10. Mai 2024, auf dem Internetportal lebensmittelwarnung.de der Bundesländer und des Bundesamtes für Verbraucherschutz veröffentlicht. Der Hersteller riet davon ab, den Toast zu essen.
Vom Rückruf betroffen sind der Mitteilung zufolge
alle Produkte mit Mindesthaltbarkeitsdaten bis einschließlich 21. Mai 2024. Die bei Edeka und Marktkauf verkauften Sandwich-Toasts seien in Nordrhein-Westfalen und angrenzenden Regionen von Niedersachsen sowie Rheinland-Pfalz verkauft worden, wie es hieß.
Am Mittwoch hatte es vom gleichen Hersteller bereits einen Rückruf für bei Lidl verkaufte Weizen- und Vollkorn-Sandwich-Toast der Marke „Grafschafter“ gegeben. Diese Sandwichbrote waren den Angaben zufolge bei Lidl in Deutschland ausschließlich in Nordrhein-Westfalen verkauft worden.

Kunststoff im Schinken
In den Delikatess-Rohschinken-Würfeln der Markte „Gut&Günstig“, 2 mal 125 Gramm Packung, können unter Umständen rote Kunststoffteile enthalten sein. Das Portal lebensmittelwarnung.de hat am Freitag, 10. Mai 2024, einen entsprechenden Rückruf des Herstellers Schwarzwaldhof Fleisch und Wurstwaren GmbH veröffentlicht. Verkauft wurde das Produkt bei Edeka. Betroffen sind der Mitteilung zufolge Packungen mit dem Mindesthaltbarkeitsdatum 07.06.2024 und dem im gleichen Feld stehenden Zeitstempel von 17 bis 18 Uhr. Nähere Infos gibt es hier. Kunden können die Schinkenwürfel zurückbringen und erhalten ihr Geld zurück. Andere Artikel und weitere Mindesthaltbarkeitsdaten oder Zeitstempel sind nicht betroffen.
KLC Geflügel Fleischwurst
Die Firma Paul Daut aus Rheda-Wiedenbrück ruft eine Wurst aus dem Handel zurück. Es könne nicht ausgeschlossen werden, dass die „KLC Delikatess Geflügel Fleischwurst 2x 200g“ Kunststofffremdkörper enthalte, teilte das Unternehmen in einem über das Portal Lebensmittelwarnung verbreiteten Rückruf mit.
Vertrieben wird die Fleischwurst über Kaufland auch in Niedersachsen. Bereits gekaufte Ware kann in den Filialen laut Mitteilung auch ohne Vorlage eines Kassenbons zurückgegeben werden. Das gilt für Packungen mit dem Mindesthaltbarkeitsdatum vom 17. bis 20. Mai 2024.
Harzer Schinkenwürstchen von Gmyrek Fleisch- und Wurstwaren
Bei einer Eigenkontrolle hat die Firma Gmyrek Fleisch- und Wurstwaren mit Sitz in Gifhorn in ihren Harzer Schinkenwürstchen Salmonellen nachgewiesen. Es handelt sich um die Würstchen in den 350 Gramm, in Folie eingeschweißten Verpackungen mit fünf nebeneinander liegenden Würstchen, Mindesthaltbarkeit 3. Mai 2024, Chargennummer GMYG24G0676. Das teilte das Unternehmen über das Portal Lebensmittelwarnung www.lebensmittelwarnung.de mit. Eine Salmonellen-Erkrankung äußert sich den Angaben nach innerhalb einiger Tage nach Infektion mit Durchfall, Bauchschmerzen und gelegentlich Erbrechen und leichtem Fieber. Die Beschwerden klingen in der Regel nach mehreren Tagen von selbst wieder ab. Insbesondere Säuglinge, Kleinkinder, Senioren und Menschen mit geschwächtem Abwehrsystem können schwerere Krankheitsverläufe entwickeln. Wer die Würstchen gegessen hat und schwere oder anhaltende Symptome entwickelt, sollte ärztliche Hilfe aufsuchen und auf eine mögliche Salmonellen-Infektion hinweisen.
Sich ohne Symptome vorbeugend in ärztliche Behandlung zu begeben, sei nicht sinnvoll. Weitere Informationen zum Krankheitserreger finden Sie hier: http://www.infektionsschutz.de/erregersteckbriefe/salmonellen
Sonnenblumenkerne von „Gut Bio“
Für die bei Aldi verkauften „Gut Bio Sonnenblumenkerne“ in der 650-Gramm-Packung gibt es einen Rückruf: Im Rahmen von Eigenuntersuchungen seien im Produkt Salmonellen positiv nachgewiesen worden, teilte der Hersteller Estyria Naturprodukte am Dienstag, 23. April 2024, über das Portal lebensmittelwarnung.de mit. Der Rückruf bezieht sich demnach ausschließlich auf Produkte mit der Chargennummer 23007616/1 mit dem Mindesthaltbarkeitsdatum März 2025. Diese sind der Mitteilung zufolge bei Aldi Nord in den Gesellschaften Rinteln, Lingen, Hann. Münden und Großbeeren sowie bei Aldi Süd in den Bundesländern Bayern, Baden-Württemberg, Saarland sowie in Teilen von Rheinland-Pfalz, Hessen und Thüringen verkauft worden.
Bionutra Moringa Pulver: Salmonellengefahr
Wer das Nahrungsergänzungsmittel Bionutra Moringa Pulver im Haus hat, sollte davon unter Umständen besser die Finger lassen: Das Unternehmen hat einen Rückruf wegen einer möglichen Salmonellenbelastung gestartet. Konkret davon betroffen ist einer Mitteilung vom Freitag, 5. April 2024, zufolge die 250-Gramm-Packung im beigefarbenen Papierbeutel mit grau-weißem Etikett und dem Haltbarkeitsdatum 24. August 2025. Die Warnung wurde auf dem Portal lebensmittelwarnung.de veröffentlicht. Das Produkt wurde demnach in fast allen Bundesländern verkauft.
Eine Salmonellenerkrankung macht sich innerhalb weniger Tage nach der Infektion bemerkbar – mit Durchfall, Bauchschmerzen, gelegentlich mit Erbrechen und leichtem Fieber. In der Regel klingen die Beschwerden nach einigen Tagen wieder ab. Für Säuglinge, Kleinkinder, Senioren und Personen mit einem geschwächten Immunsystem kann eine Erkrankung aber gefährlich werden.
Schimmelpilz-Verunreinigung in LevlUp-Getränk
Eine Charge des Getränks Hydration Drink Galaxy der Marke LevlUp enthält Verunreinigungen mit Schimmelpilzen. Das teilte das Bundesamt für Lebensmittelsicherheit am Freitag, 22. März 2024, mit. Betroffen sind den Angaben nach 500-Milliliter-Getränkeflaschen mit dem Mindesthaltbarkeitsdatum 31. Oktober 2024 und der Chargennummer L431. Beim Verzehr des Produktes aus Göttingen könne es zu Übelkeit und Erbrechen kommen.
Die Produkte mit der violetten Verpackung sind demnach in den Bundesländern Bayern, Baden-Württemberg, Berlin, Hamburg, Hessen, Nordrhein-Westfalen, Niedersachsen, Rheinland-Pfalz, Sachsen, Sachsen-Anhalt, Schleswig-Holstein und Thüringen zu finden.

Tiefkühlspinat von Ardo
Metallspäne im Spinat - das ist der Grund für den neuesten bundesweiten Lebensmittelrückruf. Betroffen sind Produkte des Herstellers Ardo, der unter anderem für Netto und Edeka produziert.
Es geht dabei um diese Sorten:
- „Edeka Junger Spinat gehackt“, 450 Gramm, tiefgefroren (Mindesthaltbarkeitsdatum 12/2025),
- „Netto Marken-Discount Beste Ernte Junger Spinat gehackt“, 450 Gramm, tiefgefroren (MHD 12/2025 und 01/2026),
- „Rewe Beste Wahl, Junger Spinat gehackt“, 450 Gramm, MHD 01/2026, Produktionschargen 144003 und 144004,
- „Rewe Beste Wahl, Junger Spinat gehackt“, 450 Gramm (MHD 12/2025 und 01/2026).
Es könne nicht ausgeschlossen werden, so heißt es in der Mitteilung des Unternehmens, dass sich in einzelnen Verpackungen dieser Produkte Metallspäne befänden. Vom Verzehr werde abgeraten. Die Packungen können in den Supermärkten zurückgegeben werden, in denen sie gekauft wurden. Auch ohne Kassenbon. Der Kaufpreis werde erstattet.
Smoothies von Lidl, Netto und Dr. Oetker
Die Molkerei Gropper hat am Donnerstag, 7. März 2024, Smoothies zurückgerufen, die bei Lidl und Netto verkauft wurden. Betroffen sind bestimmte Flaschen der Sorten „Solevita Smoothie Red Genius“ von Lidl und „Kingsway Banane-Traube-Cranberry-Granatapfel-Acai“ von Netto.
In einigen der Smoothies sei Aroniasaft enthalten, der mit Patulin belastet ist. Weiter heißt es auf dem amtlichen Portal lebensmittelwarnung.de: „Patulin ist eine von Schimmelpilzen gebildete gesundheitlich bedenkliche Substanz (Mykotoxin), welche zu Übelkeit, Erbrechen und Verdauungsstörungen führen kann.“
Konkret geht es um diese Produkte:
- „Solevita Smoothie Red Genius“ in der 250-Milliliter-Flasche mit den Mindesthaltbarkeitsdaten 13. und 14. März 2024, deutschlandweit bei Lidl in den Verkauf gebracht. Weitere Infos hier.
- „Kingsway Banane-Traube-Cranberry-Granatapfel-Acai und andere Früchte“, Mindesthaltbarkeitsdatum 12. März, verkauft in dem Discounter mit dem gelb-schwarzen Logo in Bayern, Nordrhein-Westfalen und Mecklenburg-Vorpommern. Weitere Infos hier.
Wer solche Produkte der Molkerei Gropper gekauft hat, sollte sie keinesfalls trinken. Die Flaschen können in den jeweiligen Filialen der Discounter zurückgegeben werden, auch ohne Kassenzettel.

Probleme gibt es auch mit Smoothies in Schälchen von Dr.Oetker. Das Unternehmen hat ebenfalls am 7. März einen Rückruf gestartet. Betroffen ist die „Smoothie Bowl mit Erdbeer, Banane, Aronia und Leinsamen“ mit dem Mindesthaltbarkeitsdatum bis 23. April 2024. Die Produkte sind laut Dr. Oetker seit Januar in Deutschland, Österreich und Finnland zum Verkauf angeboten worden und können dort zurückgegeben werden. Grund für den Rückruf sind auch hier mögliche Patulin-Rückstände. Weitere Infos dazu gibt es hier. Weitere Produkte aus dem Sortiment seien nicht betroffen, so Dr. Oetker.
Veganes Hack von Rückenwalder
Das Produkt „Veganes Mühlen Hack Mix und Fertig“, mit Mindesthaltbarkeitsdatum 31.01.2025 wird vom Bad Zwischenahner Lebensmittelkonzern Rügenwalder zurückgerufen. Wie das Unternehmen am 1. März 2024 auf seiner Webseite mitteilte, wurden die Produkte der betroffenen Charge bundesweit in den Filialen von Rewe, Edeka, Globus sowie über die Großer Kern GmbH verkauft.

Bei dem Rückruf handele es sich um eine rein vorsorgliche Maßnahme. Bei den Produkten der betroffenen Charge könne nicht ausgeschlossen werden, dass in diesen Salmonellen enthalten sind. Da die Produkte laut Anweisung vor dem Verzehr erhitzt werden müssen, bestehe bei ordnungsgemäßer Zubereitung kein Risiko. Trotzdem wird von dem Verzehr dringend abgeraten.
Wer das Produkt gekauft hat, kann sich den Kaufpreis im Markt auch ohne Vorlage des Kassenbons erstatten lassen. Außerdem ist eine Rückgabe online möglich. Hierfür müssen Kunden ine E-Mail an support@korodrogerie.de mit dem Betreff „Rückruf KoRo Veganes Mühlen Hack“ senden. Zusätzlich muss ein Foto der Verpackung, auf dem das Mindesthaltbarkeitsdatum erkennbar ist, und die jeweilige Bankverbindung, auf die der Kaufbetrag erstattet werden soll, angehängt werden.
:
Metallteile: Rückruf von Keksen
Das Unternehmen Banketbakkerij Merba B.V. hat am Mittwoch, 21. Februar 2024, bundesweit verschiedene Kekssorten zurückgerufen. Der Grund: Die Packungen könnten Metallfremdkörper enthalten. Die betroffenen Produkte sind nach Angaben des Unternehmens sofort aus dem Verkauf genommen worden. Bereits vor wenigen Tagen hatte es wegen dieses Problems einen Rückruf von Produkten dieses Herstellers gegeben.

Vom Rückruf betroffen sind Chargen dieser Marken mit Mindesthaltbarkeitsdatum bis zum 12. Dezember 2024:
- „Biscotto Premium Cookies Triple Chocolate 200g“ (Aldi Nord)
- „Biscoteria Triple Choc Cookies mit Vollmilch-, Zartbitter- u. weißer Schokolade 200g“ (Netto Marken-Discount).
Betroffen sind außerdem Produkte dieser Marken mit einem Mindesthaltbarkeitsdatum bis zum 13. Dezember 2024:
- „Ja! American Style Cookies Chocolate Chips 225g“ (Rewe)
- „COVO Classic Cookies 225g“ (Penny).
Der Rückruf gilt auch für die „K-Classic American Style Cookies Schokolade 225g“ mit einem Mindesthaltbarkeitsdatum bis zum 14. Dezember 2024. Sie wurden bei Kaufland zum Verkauf angeboten.
Wer eine Kekspackung der betroffenen Chargen gekauft hat, kann sie in den jeweiligen Supermärkten zurückgeben. Der Kaufpreis wird auch erstattet, wenn man den Kassenbon nicht mehr hat.
Risiko für Allergiker: Rückruf von Brot
Das Unternehmen Aerzener Brot und Kuchen GmbH aus der Nähe von Hameln hat am Dienstag, 20. Februar 2024, einige Chargen des Brotes „Rewe Bio Das Pure 300 g“ vorsorglich zurückgerufen. Der Grund: Es sind Karotten und Walnüsse enthalten, aber nicht auf der Verpackung ausgewiesen. Das kann für Menschen mit einer Walnussallergie gefährlich werden.
Vom Rückruf betroffen sind nach einer Mitteilung des Unternehmens auf dem Portal www.lebensmittelwarnung.de nur Brote mit dem Mindesthaltbarkeitsdatum 24. Juli 2024.
Das Brot war in fast allen Bundesländern erhältlich. Es wurde inzwischen aus dem Verkauf genommen. Wer das Produkt gekauft hat, kann es im jeweiligen Supermarkt zurückgeben. Der Kaufpreis wird auch ohne Vorlage des Kassenbons erstattet.

Metallteile: Rückruf von Keksen
Weil Metallteile in die Packungen geraten sein könnten, hat die niederländische Firma Banketbakkerij Merba am Freitag, 16. Februar, vorsichtshalber Kekse verschiedener Marken aus dem Verkauf zurückgezogen.
Betroffen sind unter anderem diese Produkte:
- „Edeka Cookies Triple Chocolate“, 200 Gramm, Mindesthaltbarkeitsdatum 6. Dezember 2024, Losnummer L2334103
- „Sondey Soft Baked Cookies Weisse Schokolade & Zitrone“, Lidl, 210 Gramm, Mindesthaltbarkeitsdatum 13. Dezember 2024,Losnummer L2334809.
- „Biscotto Soft Baked Cookies Triple Choc“, 210 Gramm, Mindeshaltbarkeitsdatum 12. Dezember 2024, L2334703.
Verkauft wurden die betroffenen Kekse nicht nur bei Edeka und Lidl, sondern auch bei Rewe, Kaufland, Netto, Netto Markendiscount, Penny, Tegut, Famila Nordost sowie bei den Großhändlern Markant und Metro. Eine Auflistung aller betroffenen Produkte ist hier zu finden. Vom Rückruf betroffene Packungen können auch ohne Vorlage des Kassenbons in den jeweiligen Supermärkten zurückgegeben werden.